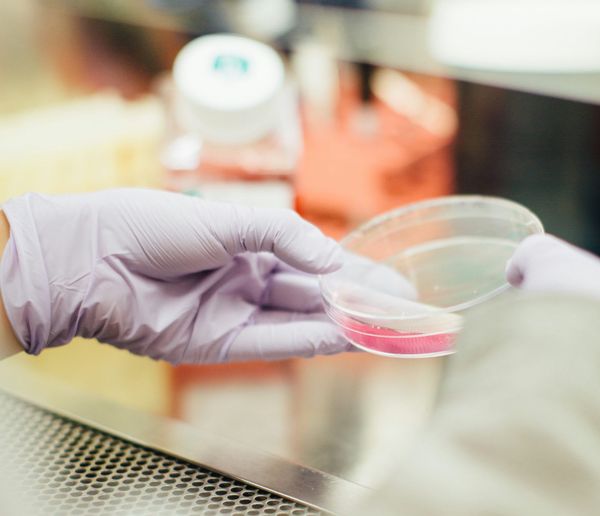
You’re Not Just a Practitioner - You’re a Translator

Health
Goodbye Guesswork: The New Era of Personalized Health
AI models now integrate nutrition, genetics, sleep, and lifestyle data to predict what interventions will actually stick. For practitioners, this means moving from guesswork to evidence-based personalization.